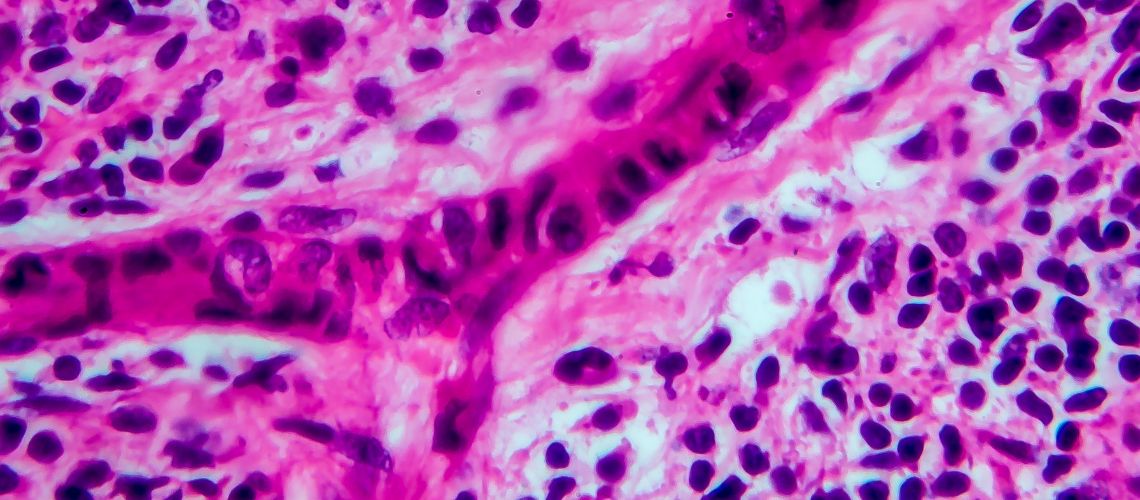
Linfoma de Hodgkin: Entendiendo la Enfermedad y su Tratamiento

Entregas GRATIS en MTY comprando mas de $400.00
$0.00
Envío Gratis Todo México comprando Más de $850.00
Categoría: SaludyBelleza
Café Con Ginseng
Energinseng Café con ginseng: El Suplemento Natural para Potenciar la Energía y la Función Íntima ¿Buscas una solución natural para aumentar tu energía y mejorar tu función íntima? Energinseng Café con Ginseng podría ser la respuesta que necesitas. Este suplemento combina ingredientes naturales como el café, el ginseng y el café verde para ofrecerte una
Como ayuda el Omega 3 6 9 al sistema circulatorio en el ser humano
El Omega-3, Omega-6 y Omega-9 son ácidos grasos esenciales que tienen un impacto positivo en la salud cardiovascular. El Omega-3 ayuda a reducir la inflamación y los niveles de triglicéridos en la sangre, mientras que el Omega-6 y el Omega-9 ayudan a mantener la integridad de las paredes arteriales y a prevenir la formación de
15 consejos para iniciar una dieta de perdida de peso
Establecer metas realistas y alcanzables. Hacer un plan de alimentación saludable que incluya una variedad de frutas, verduras, proteínas magras y carbohidratos complejos. Aumentar el consumo de agua y disminuir el consumo de bebidas azucaradas y alimentos procesados. Hacer ejercicio regularmente, buscando un equilibrio entre cardio y entrenamiento de resistencia. Buscar apoyo en amigos y
¿Qué es la grenetina hidrolizada?
El Colágeno Hidrolizado: Un Aliado para la Salud de Nuestro Cuerpo A medida que envejecemos, nuestro cuerpo enfrenta una disminución en la capacidad de producir colágeno, una proteína esencial para la salud de la piel, las articulaciones y los huesos. Esta capacidad se reduce hasta en un 60% al llegar a la edad adulta avanzada,
Linfoma de Hodgkin: Entendiendo la Enfermedad y su Tratamiento
Escuchar artículo Introducción En este artículo, abordaremos de manera exhaustiva y detallada el linfoma de Hodgkin, una forma específica de cáncer que afecta el sistema linfático. Nuestro objetivo es proporcionar una comprensión completa de esta enfermedad y su tratamiento, con el fin de brindar información valiosa a los pacientes, familiares y profesionales de la
Categorías
- General (80)
- Herbolaria (141)
- Mensajes Importantes (12)
- Probióticos (10)
- Recetas Saludables (14)
- Salud Digital (2)
- SaludyBelleza (252)
- Tecnología (6)